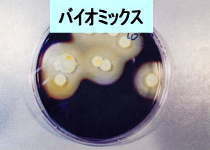
バチルス菌の写真

バイオミックスは自然界の浄化の主役とし、今脚光を浴びている納豆菌バチルスを中心に
菌の働きを助けるミネラルや独自の,活性促進剤などを混合した、環境浄化を目的とした商品です。
中心となる納豆菌バチルスは土壌中や枯草に存在し、
枯草菌ともよばれています
食品では納豆,味噌、醤油などにもあるごくありふれた菌ですが、
そのなかでも分解、脱臭に抜群の能力をもったバチルス種の菌が選別されています。
その他、納豆菌バチルスは自らの優位性を維持するために他の細菌,病原菌の生育を妨げる働きがあることで知られています。
大腸菌やカビなどが繁殖しにくくなることはよく知られています。
|
胞子と発芽した活性細胞 |
バイオ原液に使われている納豆菌バチルスは 下水処理浄化槽で抜群の効果のあった菌を選別したものです。 どの状況でも納豆菌バチルスが残っていたといったほうが適切かもしれません。 それゆえ分解能力は抜群です。 |
 1.5ミクロンの戦士たち(バチルス菌) 電子顕微鏡35000倍の世界 |
左の写真は納豆菌バチルス単体の姿です。 下にある白い線の長さはは0.5ミクロンです。 バイオ原液1cc中に10の10乗、100億個ぐらい存在しています。 この小さな微生物が悪臭を分解し、カビを退治してくれるます。 この写真に何故か感動的なものを私は覚えました。 環境のために戦ってくれる 0.5ミクロンの小さな戦士たちです。 |
バイオミックスには 納豆菌バチルス(枯草菌)だけでもいろいろな種類の菌が混ざっています。
それらが競い合って増殖のスピードを上げていきます。
単菌だけのものよりある種の逞しさがあると考えて下さい。
ですから、色々な油、廃棄物が流入するグリストラップや生ごみ処理に力を発揮できます。
※グリストラップ :
業務用厨房から出される排水は、一旦、浄化槽で油分や汚水を浄化してから下水に流す事が義務付けられています。
特に厨房内にある浄化槽は主として油分(グリス)を止める(トラップ)ということでグリストラップと呼ばれています。
グリストラップの成分例
納豆菌バチルスはグラム中、10の7乗10,000,000個以上あります。
全窒素 2,7%
全リン 2.1%
カリウム2.1%
全炭素14.9%
(予告なく活性促進剤、ミネラル分を混合比率を変える場合があります。)
納豆菌バチルスとは
納豆菌バチルスは自然界の浄化作用の主役、土壌中どこにでも生息しています。
糖質/でん粉、蛋白質,脂肪など有機物を分解・摂取する
(特にでん粉を分解できる菌は少ないといわれています。)
バイオミックスではバチルス菌の中でも
分解能力の高いバチルス菌を選別して使っています。

上の写真は澱粉分解テスト結果です。
コロニー(白いかたまり)の周りまで分解してる様子がわかります。
クックドミート分解テストではたんぱく質の分解能力を確かめます。

| 1 | 2 | 3 | 4 | 5 | 6 | |
| 1日後 | 10 | 20 | 10 | 20 | 10 | 10 |
| 2日後 | 20 | 60 | 90 | 90 | 30 | 10 |
| 3日後 | 70 | 90 | 100 | 100 | 60 | 20 |
| 4日後 | 90 | 100 | 90 | 40 | ||
| 5日後 | 95 | 100 | 80 | |||
| 6日後 | 100 | 90 | ||||
| 7日後 | 100 |
普通、5日で分解できれば合格とされていますが
ここでは3日で分解できたバチルス菌3.4を採用しています。
さらに納豆菌バチルスのすぐれた能力として
アンモニア、硫化水素、メチルメルカプタンなど臭気成分を分解します。
他にバイオミックスの特徴として
増殖の速度が速い(18分から30分に1回)
環境条件に強い
(低ph・10℃から50℃ぐらいで活発に活動します。80度でも胞子状態で生息しています)
大腸菌やカビ菌など他の細菌を死滅させることで、処理細菌としての優先性を確保しています。
納豆菌バチルス(枯草菌)について
バイオミックスに含まれる納豆菌バチルスは脂肪の分解性が高く、臭気の分解ができることが特徴となっています。
その中で澱粉の分解性が高く、タンパク質の易分解性を持つのが
チューリージェンシス(B.thuringiensis)
サブチルス(B.subtilis)
です。
タンパク質の易分解性を持つプミルス(B.pumilus)も含まれています。
さらにバイオミックスには、し尿処理場で活躍している菌を単菌分離し、プラスしてあります。
性質の異なった細菌類が互いにたすけあって増殖が盛んになり、グリストラップの流入成分変動にも対応できるようになっています。
単離菌株テスト例
| 増殖温度条件 | 食物成分 | 世代時間 32℃ | |||||||||||||||
| 温度帯 | 10℃ | 11℃ | 12℃ | 13℃ | 14℃ | 15℃ | 16~39℃ | 40℃ | 45℃ | 50℃ | 55℃ | 60℃ | SS減少率 %/14day |
大豆油分解性 mg/6ml培地 |
|||
| デンプン分解 | 菌株1 | + | + | + | + | + | + | + | + | + | - | - | - | 9 | 3 | 25分 | チューリージェンシス (B.thuringiensis) |
| 菌株2 | - | - | + | + | + | + | + | + | - | - | - | - | 20 | 5 | 34分 | チューリージェンシス (B.thuringiensis) |
|
| タンパク分解 | 菌株3 | - | - | - | + | + | + | + | + | + | + | - | - | 68 | 2 | 22分 | プミルス (B.pumilus) |
| 菌株4 | - | - | - | + | + | + | + | + | - | - | - | - | 81 | 0 | 30分 | プミルス (B.pumilus) |
|







